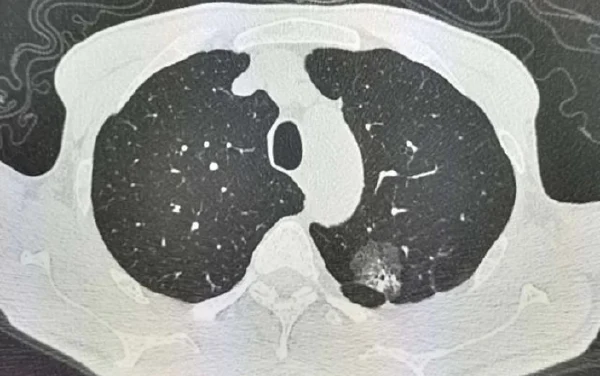
全面解析肺结节及腺癌：从诊断到管理

全面解析肺结节及腺癌:从诊断到管理
概述
本文旨在全面介绍肺结节和肺腺癌的类型、诊断流程、分期标准、治疗方式、不良反应处理及患者生活习惯调整,帮助读者建立科学的疾病管理观念。
肺结节和肺腺癌是临床上常见的肺部疾病,早期发现和及时治疗对预后有着重要的影响。本文将详细解析这些疾病的诊断标准、分期方法及多种治疗方案。
此外,患者在治疗过程中可能会遇到的不良反应及如何应对这些反应也将在本文中进行探讨。同时,本文还将提供一些实用建议,帮助患者更好地调整生活习惯,以提高生活质量。
肺结节和肺腺癌有哪些主要分类?
根据病因、病理生理、临床表现等角度,肺结节和肺腺癌的分类方法具有多样性。一些主要的分类方法包括良性和恶性结节,原发性和继发性肺腺癌等。
肺结节通常可分为良性和恶性两类。良性结节如炎性假瘤、钙化结节等,无需特别治疗,但需要定期随访。而恶性结节,如肺癌,则需要进一步细致检查和讨论治疗方案。
肺腺癌则可以根据其组织学类型进行分类,如浸润性非黏液性腺癌、黏液性腺癌等。进一步细分为贴壁型、腺泡型等,根据不同的组织学特点确定具体治疗策略。此外,免疫组化指标如CK7、TTF-1、NapsinA等的阳性或阴性结果,也能为临床提供重要的诊断和分类依据。
在详细分类后,能更好地制定个体化治疗方案,提高治疗的针对性和有效性,最终改善患者预后。
如何诊断肺结节和肺腺癌?
肺结节和肺腺癌的诊断通常需要综合临床表现、影像学检查、美学检验和病理结果。影像学检查包括胸部CT、PET-CT等,可以提供直观的肺部影像信息。
对于疑似恶性结节的患者,通过穿刺活检获取标本,进行病理学和免疫组化检测,明确结节的组织学类型及分级。此外,一些基因检测手段如ALK、ROS-1等,可以进一步提供治疗靶点信息。
依据最新的临床研究,影像学特征如结节大小、形状、密度等,以及病理特征如浸润性、胸膜受累等,都是判断结节性质的重要依据。影像学检查要与其他检查结果综合分析,避免单一指标误导。
依据患者的具体情况,临床医师将综合病史、影像学和病理结果,做出最合理的诊断,并制定后续治疗计划。
肺腺癌的分期与评估
肺腺癌的分期是决定治疗方案的重要步骤,通常采用国际公认的TNM分期系统。TNM分期系统根据肿瘤大小(T)、淋巴结受累情况(N)及远处转移(M)来确定。
肿瘤的病理分级也是评估的重要方面,通常分为高分化、中分化和低分化三种。分级越低,提示肿瘤恶性程度越高,预后越差。
最新研究成果指出,影像学分期(如通过CT或PET-CT确定的分期)与病理分期结合,是决定最终治疗策略的关键。术前尽可能准确的分期,有助于制定合理的手术和术后治疗计划。
治疗方式详解
肺结节和肺腺癌的治疗方法多样,取决于病变的性质和分期。良性结节通常无需治疗,而恶性结节则需进行手术、化疗、放疗或靶向治疗等。
手术治疗是早期肺腺癌的首选方法,能最大限度地切除病灶。对于无法手术的患者,放疗和化疗是重要的辅助治疗手段。此外,随着分子生物学的发展,靶向治疗和免疫治疗也成为新的治疗方向。
如何应对不良反应?
在治疗过程中,患者可能会出现各种不良反应,包括手术后的感染、化疗导致的骨髓抑制、放疗引起的放射性肺炎等。及时识别和处理这些不良反应,是保障治疗效果和患者生活质量的关键。
为减少不良反应带来的影响,应该建立完善的患者管理体系,定期随访和监测病情,调整治疗方案。同时,患者积极配合,保持良好的生活习惯,也能有效减轻不良反应。
总结要点:
总而言之,肺结节和肺腺癌的科学管理需要精确诊断、合理分期和个性化治疗。除了规范的医学治疗,患者还需保持良好的心态和生活习惯,提高整体生活质量。通过医患共同努力,能更好地对抗疾病,达到理想的治疗效果。